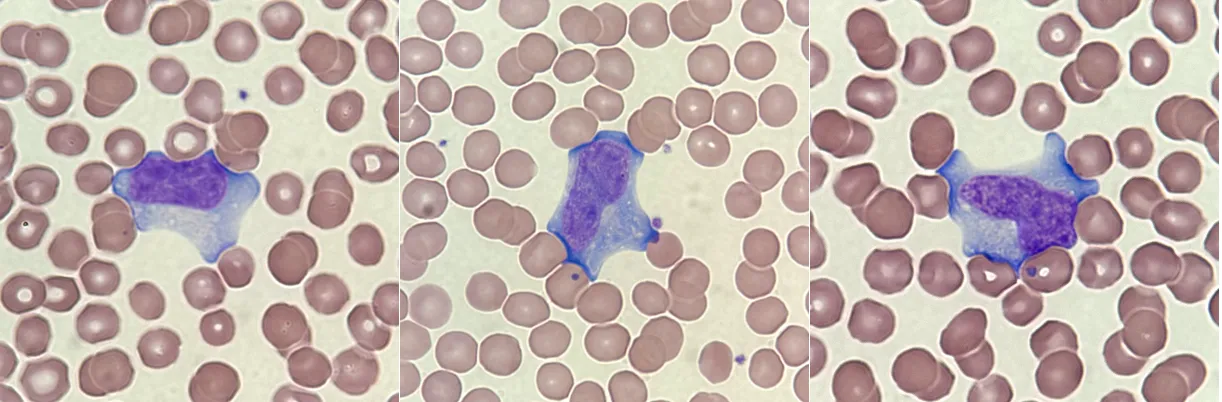

También conocido como: anticuerpos heterófilos, prueba rápida para mononucleosis, cribado del VEB, cribado del EBV
Nombre sistemático: prueba rápida de la mononucleosis infecciosa
Aspectos generales
¿Por qué hacer el análisis?
Para detectar y poder diagnosticar una mononucleosis infecciosa (MNI).
¿Cuándo hacer el análisis?
Cuando una persona, especialmente si se trata de un adolescente, presenta síntomas sugestivos de mononucleosis, como fiebre, dolor de garganta, inflamación de los ganglios linfáticos y cansancio.
¿Qué muestra se requiere?
La determinación se realiza a partir de una muestra de sangre venosa del brazo.
¿Es necesario algún tipo de preparación previa?
Para esta prueba no se necesita ninguna preparación especial.
¿Qué es lo que se analiza?
La mononucleosis infecciosa (MNI) es una infección causada por el virus de Epstein-Barr (VEB). La prueba rápida para la mononucleosis detecta un tipo de proteínas sanguíneas conocidas como anticuerpos heterófilos, producidos por el sistema inmunitario en respuesta a la infección por el VEB.
La MNI se caracteriza por un conjunto característico de signos y síntomas que se presentan sobre todo en los adolescentes. Las personas con MNI suelen tener fiebre, dolor de garganta, inflamación de los ganglios linfáticos y fatiga. En muchas ocasiones también existe un aumento del tamaño del bazo, y más raramente del hígado. Los síntomas aparecen aproximadamente al cabo de un mes de haberse producido la infección inicial y pueden durar varias semanas. La fatiga, sin embargo, puede tardar meses en desaparecer. La MNI suele ser autolimitada y resolverse sin un tratamiento específico.
El VEB es un virus de la familia herpesvirus muy común y contagioso. Se estima que la gran mayoría de la población se ha infectado por el VEB antes de los 40 años de edad. El virus se encuentra en la saliva de la persona infectada y puede transmitirse a otras personas a través de un contacto íntimo, como por un beso o por compartir vasos o cubiertos.
En la mayoría de los casos, la infección por VEB ocurre durante la infancia y no ocasiona síntomas o muy pocos. Sin embargo, si la primera exposición al virus tiene lugar durante la adolescencia, cerca de un 25% de los afectados presentará síntomas asociados a MNI. La mononucleosis puede afectar a cualquier persona y a cualquier edad, pero su prevalencia es superior entre los jóvenes, en institutos, universidades o cuarteles.
La prueba rápida de los anticuerpos heterófilos tiene una sensibilidad del 71-80%, por lo que se suele utilizar como prueba inicial de cribado para la mononucleosis infecciosa. Sin embargo, esta prueba tiene alrededor de un 25% de resultados falsos negativos debido a que algunas personas infectadas por el VEB no producen los anticuerpos heterófilos que detecta la prueba. En el caso de que la prueba rápida para la mononucleosis sea negativa, pero la sospecha clínica de la enfermedad siga siendo alta, se realiza una prueba más específica que consiste en la detección de anticuerpos frente al virus de VEB.
Esta prueba se suele acompañar de la realización de un hemograma y una extensión de sangre periférica, ya que la MNI se caracteriza por acompañarse de un aumento del recuento de leucocitos junto con la presencia de células atípicas en la extensión (se informa como linfocitosis reactiva o presencia de linfocitos reactivos, activados o estimulados).
Según los Centros de Control y Prevención de Enfermedades (CDC), otros virus que pueden causar mononucleosis son:
- Citomegalovirus (CMV).
- Hepatitis A, hepatitis B o hepatitis C.
- Virus de la inmunodeficiencia humana (VIH).
- Rubéola.
- Toxoplasmosis.
Preguntas comunes
¿Cómo se utiliza?
La prueba rápida para la detección de la mononucleosis infecciosa (MNI) se emplea para determinar si una persona con signos o síntomas puede estar padeciéndola. La prueba permite detectar unas proteínas de la sangre llamadas anticuerpos heterófilos, producidas por el sistema inmunitario en respuesta a la infección por el virus de Epstein-Barr (VEB), que es la causa más frecuente de MNI.
Suele realizarse junto con un hemograma y una extensión de sangre, para saber si existe un aumento en el recuento de leucocitos con una linfocitosis reactiva. La MNI se caracteriza por la presencia de linfocitos atípicos, también llamados reactivos, activados o estimulados (Figura 1).
Figura 1. Linfocitos atípicos observados en la extensión de sangre periférica de un paciente con MNI. Es característico de estos linfocitos el gran tamaño del citoplasma y su color basófilo, sobre todo en los bordes en contacto con los hematíes.
Si esta prueba es negativa pero la sospecha clínica de MNI sigue siendo elevada, puede repetirse la prueba al cabo de una semana para determinar si se han desarrollado ya los anticuerpos heterófilos. En el caso de que la prueba volviera a ser negativa, pueden determinarse los anticuerpos específicos frente al virus para confirmar o descartar la infección por el VEB. También puede realizarse la prueba para el estreptococo, para establecer si el dolor de garganta no es por una MNI, sino que es debido a una infección por estreptococo del grupo A (faringoamigdalitis estreptocócica).
¿Cuándo se solicita?
La prueba rápida para la detección de mononucleosis se solicita principalmente cuando una persona, especialmente si se trata de un adolescente, presenta síntomas sugerentes de la mononucleosis infecciosa (MNI). Los signos y síntomas pueden confundirse con los de los resfriados, anginas o gripe. Entre ellos se incluyen:
- Fiebre.
- Dolor de cabeza.
- Dolor de garganta.
- Inflamación de los ganglios linfáticos del cuello y de las axilas.
- Debilidad y fatiga progresivas.
Algunas personas pueden presentar además:
- Dolor de estómago.
- Aumento del tamaño del bazo o del hígado.
- Erupción cutánea.
La prueba puede repetirse al cabo de unos días si ha sido inicialmente negativa y la sospecha clínica de MNI sigue siendo elevada.
¿Qué significa el resultado?
Un resultado positivo para la prueba rápida de la mononucleosis, acompañado de un aumento del recuento de leucocitos y la presencia de linfocitos reactivos en la extensión de sangre, además de los signos asociados a la enfermedad indican con gran probabilidad de que exista una mononucleosis infecciosa (MNI).
Un resultado negativo para esta prueba debe interpretarse con precaución:
- Si existen síntomas y linfocitos reactivos pero la prueba rápida es negativa, es posible que sea demasiado pronto para que el organismo haya tenido tiempo de producir los anticuerpos heterófilos, o es posible que se trate de uno de los pocos casos en los que no se producen dichos anticuerpos heterófilos. La prueba puede repetirse al cabo de unos días o bien determinar los anticuerpos específicos frente al virus de Epstein-Barr (VEB), para confirmar o descartar la enfermedad.
- La mayoría de los bebés y niños no desarrollan los anticuerpos heterófilos y por lo tanto la prueba rápida para la mononucleosis resulta negativa, aunque estén infectados por el VEB. En estos casos, la medición de anticuerpos específicos resulta más efectiva. Sin embargo, es raro que se les realice la prueba, ya que no suelen desarrollar los síntomas de MNI.
- Cuando existen síntomas compatibles pero la prueba rápida es negativa y no se detectan linfocitos reactivos, es posible que el responsable de la MNI sea un microorganismo diferente del VEB, como el citomegalovirus (CMV) o el toxoplasma. Si la infección se produce durante el embarazo, es muy importante determinar exactamente la causa de la enfermedad, ya que algunas de estas infecciones se asocian a la presencia de complicaciones del embarazo y a daño fetal. También es importante identificar si las molestias se deben a una infección por estreptococo (faringitis o faringoamigdalitis), porque en estos casos se debe administrar un antibiótico. Los virus no responden al antibiótico, por lo que no se debe administrar si son la causa de la MNI.
¿Hay algo más que debería saber?
La prueba de detección o de cribado de mononucleosis es rápida y sencilla, pero es específica para los anticuerpos heterófilos y no para los anticuerpos frente al virus de Epstein-Barr (VEB). Por ello, se recomienda no realizar un diagnóstico basado exclusivamente en el resultado de esta prueba y tener en cuenta el contexto clínico del paciente.
Si la prueba de la mononucleosis es negativa pero el médico necesita más información acerca de la posible infección por el VEB, puede solicitar uno o varios anticuerpos frente al VEB. Estos anticuerpos pueden indicar si la persona es susceptible a la infección por VEB, si ha tenido una infección recientemente, tuvo una infección previa o tiene una reactivación de la infección por el VEB.
Los anticuerpos heterófilos disminuyen al cabo de unas cuatro semanas, por lo que la prueba rápida para la mononucleosis se negativiza al resolverse la infección.
También se puede detectar el VEB cuantificando su ADN en sangre o plasma mediante la reacción en cadena de la polimerasa (PCR), aunque no se recomienda en pacientes inmunocompetentes debido a su escasa utilidad clínica.
El VEB puede afectar al hígado y causar una elevación de las enzimas hepáticas, por lo que otras pruebas útiles en el contexto de la MNI son la determinación de la alanina aminotransferasa (ALT) y la aspartato aminotransferasa (AST), además de los marcadores de inflamación como la proteína C reactiva.
¿Es muy grave la mononucleosis infecciosa (MNI)?
Los síntomas de la enfermedad suelen resolverse al cabo de uno a cuatro meses con un tratamiento de soporte, aportando líquidos y guardando reposo. A veces, el tamaño del hígado o del bazo aumenta, incluso puede acabar en la rotura de éste último (complicación rara, pero grave de la MNI), por lo que se debe limitar la actividad normal y hacer reposo hasta que se recupera el tamaño normal de estos órganos. Muy raramente, pueden existir complicaciones del corazón o del sistema nervioso central. En los varones portadores del gen XLP, la MNI puede ocasionar un fallo hepático grave que podría tener un desenlace fatal.
¿Es cierto que la mononucleosis se transmite con los besos?
Para que el virus de Epstein-Barr (VEB) se propague es necesario el contacto con saliva de una persona infectada, como puede suceder al besarse. Sin embargo, la infección puede contraerse de otras maneras, como por ejemplo por compartir chupetes o juguetes entre los niños pequeños, botellas de agua, vasos, cepillos dentales, o incluso a través de las mismas manos. La transmisión del virus a través del aire o de la sangre no suele constituir una vía común de infección. El período de incubación de la enfermedad (tiempo que transcurre desde la infección hasta que aparecen los síntomas), es de 4 a 6 semanas.
Las personas con la MNI pueden transmitir la infección durante varias semanas. Muchas personas sanas previamente infectadas por VEB pueden ser portadoras del virus y propagarlo de manera intermitente durante toda la vida; realizar los análisis a estas personas no resulta práctico. Por esta razón se considera prácticamente imposible evitar la propagación del virus. Además, casi todas las personas mayores de 40 años se habrán infectado con el VEB, aunque ello no significa que hayan desarrollado una MNI.
Actualmente, no existen vacunas disponibles comercialmente para prevenir la infección del VEB.
¿Puede el virus de Epstein-Barr ser la causa del síndrome de fatiga crónica?
Por ahora, no existe ninguna evidencia analítica que indique que la infección por el virus de Epstein-Barr sea la causa del síndrome de fatiga crónica. Para más información, consultar el artículo en la web de los Centros para el Control y la Prevención de Enfermedades (CDC) sobre el síndrome de fatiga crónica.
¿Se puede contraer la mononucleosis en más de una ocasión?
A pesar de que los síntomas de la MNI desaparecen en 1 o 2 meses, el virus de Epstein-Barr permanece inactivo en algunas células del organismo durante toda la vida. El virus se puede reactivar periódicamente y puede detectarse en la saliva de personas infectadas. Esta reactivación suele tener lugar sin síntomas asociados a la enfermedad.
¿Qué otras enfermedades puede producir el virus de Epstein-Barr?
El virus de Epstein-Barr se ha asociado a ciertos cánceres, como el linfoma de Burkitt, enfermedad de Hodgkin, carcinoma nasofaríngeo y linfoma asociado al SIDA. También se está investigando la posible relación causal entre la infección por el virus y el desarrollo de enfermedades autoinmunes como la esclerosis múltiple y el lupus eritromatoso sistémico, tras haberse demostrado una fuerte asociación entre ellas. Se sigue estudiando la posible asociación del virus con otros tipos de cáncer. La incidencia de estas enfermedades es baja, y en el caso del linfoma de Burkitt o el carcinoma nasofaríngeo, son muy poco habituales en nuestro entorno.
Enlaces
Pruebas relacionadas:
Virus Epstein-Barr anticuerpos
Citomegalovirus (CMV)
Análisis del líquido cefalorraquídeo
Estados fisiológicos y enfermedades:
En otras webs:
Sociedad Española de Medicina Interna (SEMI): Mononucleosis infecciosa
Clínica Universidad de Navarra (CUN): Mononucleosis infecciosa
Medline: Prueba rápida para mononucleosis
Manual MSD: Mononucleosis infecciosa
También conocido como: HSV-1, HSV-2, HHV1, HHV2, VHS, herpes oral, herpes labial, herpes genital
Nombre sistemático: virus del herpes simple tipo 1 y tipo 2
Aspectos generales
¿Por qué hacer el análisis?
Para hacer un cribado o un diagnóstico de la infección por el virus del herpes simple (VHS).
Pregúntenos





